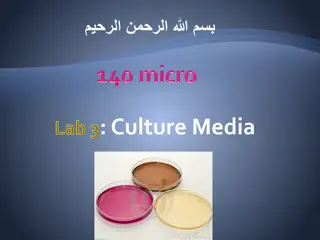

Foils in Literature and Media
A foil is a character in a story that contrasts with another character, often the protagonist, to highlight their qualities. It can be completely opposite or similar with a key difference. Foils are used to emphasize specific traits of the main character without being the antagonist. Examples of foils include Marlin and Dory from Finding Nemo, Sherlock Holmes and John Watson, and more. This concept can be explored in various books, movies, and shows to deepen character dynamics.
Download Presentation

Please find below an Image/Link to download the presentation.
The content on the website is provided AS IS for your information and personal use only. It may not be sold, licensed, or shared on other websites without obtaining consent from the author.If you encounter any issues during the download, it is possible that the publisher has removed the file from their server.
You are allowed to download the files provided on this website for personal or commercial use, subject to the condition that they are used lawfully. All files are the property of their respective owners.
The content on the website is provided AS IS for your information and personal use only. It may not be sold, licensed, or shared on other websites without obtaining consent from the author.
E N D
Presentation Transcript
What is a foil? a character that has characteristics that oppose another character, usually the protagonist
What is a foil? The foil character may be completely opposite to the protagonist, or very similar with one key difference.
Why is a foil used? The foil character is used to highlight some particular quality or qualities of the main character.
Is a foil an antagonist? Not always! The key difference between the foil and antagonist is that the antagonist s actions oppose the protagonist while the foil s character is in opposition to the protagonist.
This presentation included several examples of foils Marlin and Dory Lightening McQueen and Mater Sherlock Holmes and John Watson Carly and Sam Can you think of any examples in a book, movie, or show you enjoy?
Watch the clip again. Then, on your notes, explain how Dory (blue fish) is a foil of Marlin (clown fish). https://www.youtube.com/watch?v=nYfOPAI-LWE
Look at the sheet comparing Esperanza to Sally turn and talk. How is Sally a foil to Esperanza? How does Sally highlight some particular quality or qualities of Esperanza?
Read What Sally Said, Red Clowns, and Linoleum Roses And answer the question: how do these chapters further prove that Sally is Esperanza s foil?
Homework: Read Bums in the Attic , The Three Sisters , and Alicia and I Talking on Edna s Steps and do the back of the foils worksheet